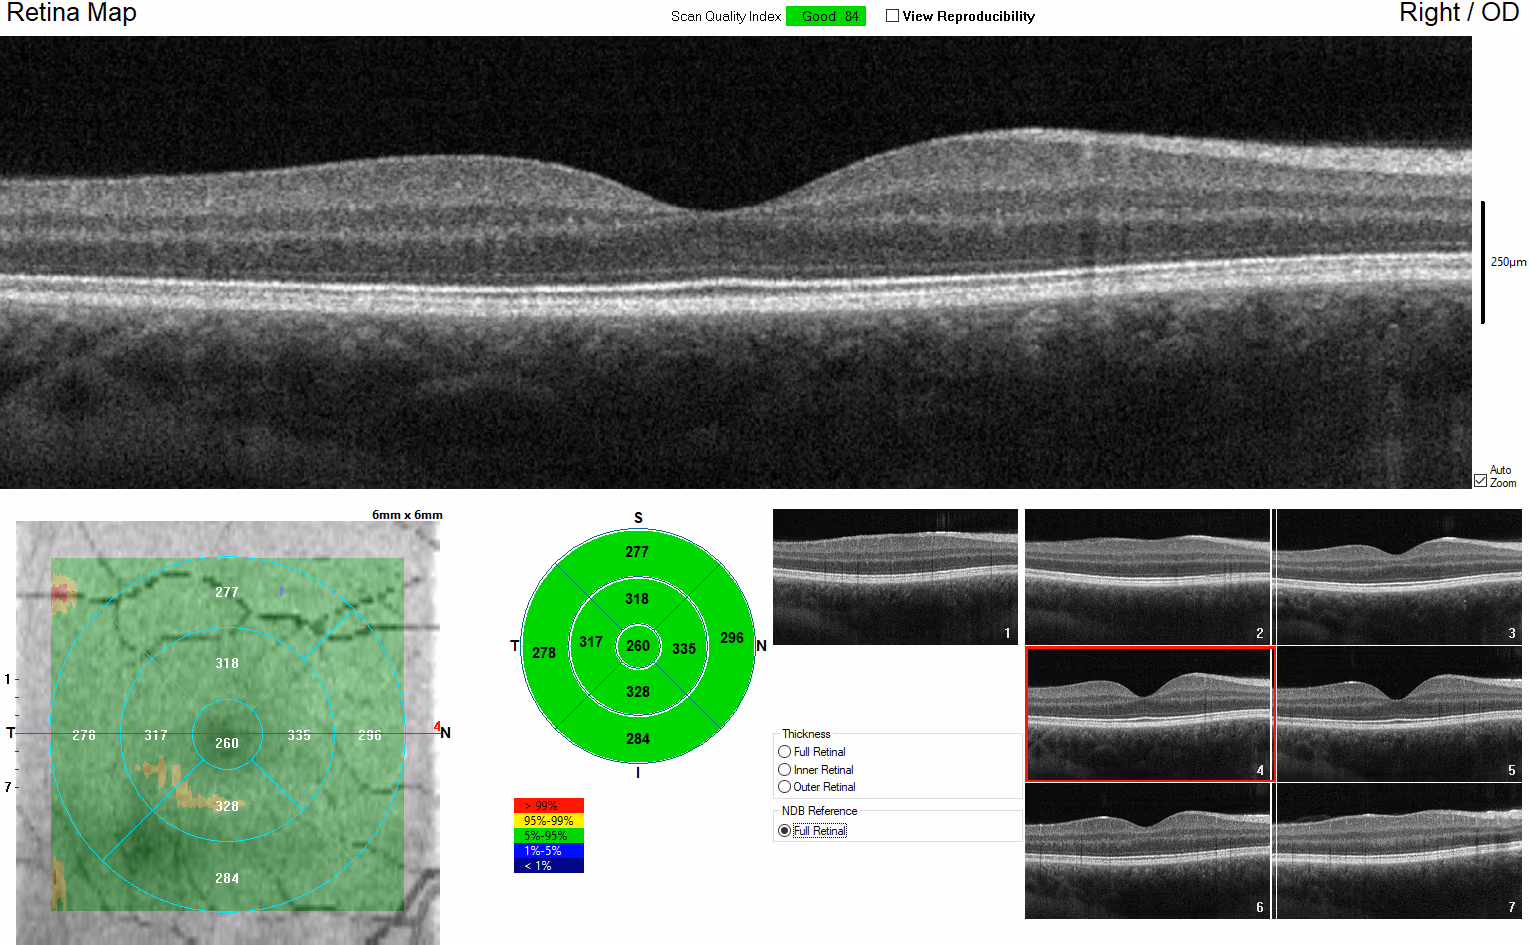
OCT de mácula saudável, com a depressão foveal normal e as camadas retinianas bem organizadas.

Como funciona e para quem costuma ser indicada
Por Dr. Daniel Lani Louzada

Este guia explica tudo o que você precisa saber sobre a cirurgia de membrana epirretiniana (MER): quando ela é indicada, como decidir se é o caminho certo para você, o que acontece durante o procedimento e como é a recuperação. Também abordamos taxas de sucesso, possíveis riscos e sinais de alerta no pós-operatório, para que você tenha informações práticas e claras para tomar uma decisão informada sobre a sua saúde visual.